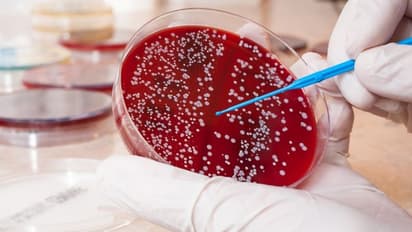

ക്യാന്സര് പല തരത്തിലും രൂപത്തിലുമുണ്ട്. ക്യാന്സറുകളില് മാരകമായ ഒന്നാണ് രക്താര്ബുദം അഥവാ ബ്ലഡ് ക്യാന്സര്. ബ്ലഡ് ക്യാന്സര് പലപ്പോഴും ആദ്യം തിരിച്ചറിയാന് സാധിക്കില്ലെങ്കിലും പലപ്പോഴും ശരീരം തന്നെ ചില ലക്ഷണങ്ങള് കാണിക്കാറുണ്ട്. ലുക്കീമിയ എന്ന പേരിലും ഇത് അറിയപ്പെടുന്നു. ഈ രോഗം ഉള്ളവരില് രക്തത്തിലെ ഹീമോഗ്ലോബിന്റെ അളവ് പെട്ടെന്ന് കുറഞ്ഞുക്കൊണ്ടിരിക്കും ഇത് വിളര്ച്ചയ്ക്കും ക്ഷീണത്തിനും കാരണമാകും. എപ്പോഴും തളര്ച്ചയും തലകറക്കവും അനുഭവപ്പെടുന്നെങ്കില് ഡോക്ടറെ കണ്ടു പരിശോധനകള് നടത്തണം. ലുക്കീമിയ പിടിപെടുന്നവരില് രക്തത്തിലെ പ്ലേറ്റ്ലെറ്റിന്റെ അളവ് ക്രമാതീതമായി കുറയും. ഇങ്ങനെ സംഭവിക്കുമ്പോള് രക്തക്കുഴലുകള് പൊട്ടി രക്തസ്രാവം ഉണ്ടാകും.
ഇടയ്ക്കിടെ വരുന്ന പനിയാണ് രക്താര്ബുദത്തിന്റെ മറ്റൊരു ലക്ഷണം. രോഗം കോശങ്ങളുടെ പ്രതിരോധശേഷി നശിപ്പിക്കുന്നതാണ് ഇതിന്റെ കാരണം. കാരണമില്ലാതെ രാത്രിയില് വിയര്ക്കുക, ഭാരം പെട്ടെന്ന് കുറയുക, മൂക്ക്, വായ, മലദ്വാരം, മൂത്രദ്വാരം എന്നിവിടങ്ങളില് നിന്നുള്ള അസ്വഭാവിക ബ്ലീഡിങ് എന്നിവയും സൂക്ഷിക്കണം.
തലവേദന, ചര്മത്തിലും വായിലും മറ്റുമുണ്ടാകുന്ന തടിപ്പുകളും വ്രണങ്ങളും, എല്ലുകളിലും സന്ധികളിലുമുണ്ടാകുന്ന വേദന എന്നിങ്ങനെയുള്ള എല്ലാ ലക്ഷണങ്ങളും ശ്രദ്ധിക്കേണ്ടതാണ്. എല്ലായ്പ്പോഴും ഇത് ക്യാൻസറിന്റെ ലക്ഷണങ്ങൾ ആകണമെന്നില്ല. എങ്കിലും ഇത്തരം അവസ്ഥകള് ഉണ്ടായാല് ഒരു വിശദപരിശോധന നടത്തുക.